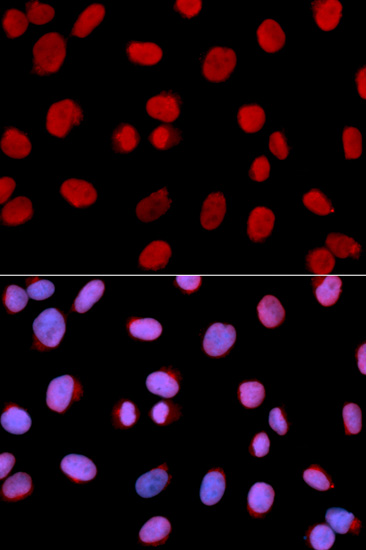

For quotations, please use our online quotation form, and you may also contact us by
sales@neoscientific.com
+1-888.733.6849
+1-617.299.7367 (Int’l)
+1-888.733.6849
+1-617.299.7367 (Int’l)
| Reactivity | Human Mouse Rat |
| Tested applications | WB IHC IF |
| Recommended Dilution | WB 1:500 - 1:2000 IHC 1:50 - 1:200 IF 1:50 - 1:200 |
| Calculated MW | 93kDa |
| Observed MW | Refer to Figures |
| Immunogen | Recombinant protein of human MCM6 |
| Storage Buffer | Store at -20℃. Avoid freeze / thaw cycles. Buffer: PBS with 0.02% sodium azide, 50% glycerol, pH7.3. |
| Synonym | Mis5; P105MCM; MCG40308; |

Western blot analysis of extracts of various cell lines, using MCM6 antibody.

Immunohistochemistry of paraffin-embedded human lung cancer using MCM6 antibody at dilution of 1:100 (400x lens).
Immunofluorescence analysis of U2OS cell using MCM6 antibody. Blue: DAPI for nuclear staining.

Immunofluorescence analysis of U2OS cell using MCM6 antibody.
The MCM genes were firstly identified in yeast defective in minichromosome maintenance and have since been shown to have roles in the progression of the cell cycle, and most of them are cell division control genes[PMID: 18096807]. MCM2-7 complex are suggested to be 'DNA licensing factors' which bind to the DNA after mitosis and enable DNA replication before being removed during S phase. Mini-chromosome maintenance 6 (MCM6) is one component of the MCM2-7 complex which is the putative replicative helicase essential for 'once per cell cycle' DNA replication initiation and elongation in eukaryotic cells[PMID: 9305914]. MCM6 single subunit forms homohexamer and contains an ATP-dependent and replication fork stimulated 3' to 5' DNA unwinding activity along with intrinsic DNA-dependent ATPase and ATP-binding activities [PMID:21336027].
N/A